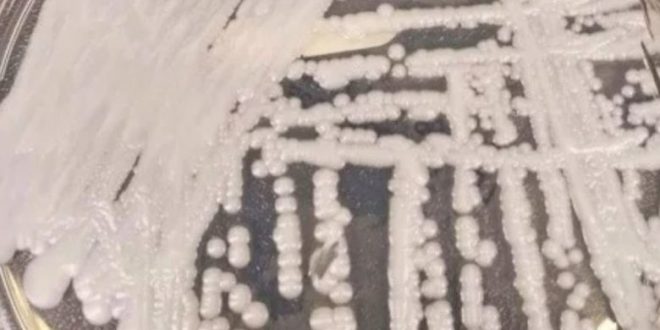

Al menos hay 10 casos del ominoso hongo Cándida auris en México, el cual, de acuerdo con autoridades sanitarias del país, es resistente a los principales medicamentos conocidos, y que puede ser mortal para el ser humano.
La Secretaría de Salud notificó que los casos detectados por infección de este hongo tienen antecedentes de neumonía por COVID-19 en correlación con la enfermedad de la pandemia.
Además, se le suman antecedentes en hospitalización en Unidad de Cuidados Intensivos de Adultos (UCIA), de ventilación mecánica, sonda urinaria, catéter venoso central, estancia prolongada y antibioticoterapia como factores clave.
Al 27 de noviembre de 2020, en el estado de Nuevo León se han identificado 34 colonizaciones(aislamientos de C. auris sin datos clínicos) y diez infecciones por C. auris en pacientes hospitalizados, cinco identificadas en el torrente sanguíneo y cinco en vías urinarias, explicó la dependencia en un aviso epidemiológico”, aseveraron los expertos.
Cabe mencionar que la Cándida auris es un tipo de hongo que puede causar enfermedades graves en pacientes hospitalizados, ya que las infecciones por ello son difíciles de tratar.
C. auris apareció recientemente en los Estados Unidos y los funcionarios de salud pública están investigando más sobre cómo se transmite. Además, ya se registraron los primeros casos en Brasil.
Con información de Debate
 Yucatán al Instante Noticias al Instante
Yucatán al Instante Noticias al Instante